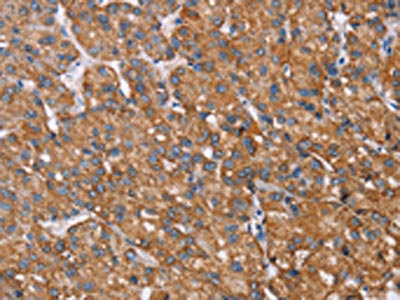

RMDN3 Antibody
-
中文名稱:RMDN3兔多克隆抗體
-
貨號:CSB-PA265524
-
規(guī)格:¥1100
-
圖片:
-
The image on the left is immunohistochemistry of paraffin-embedded Human liver cancer tissue using CSB-PA265524(RMDN3 Antibody) at dilution 1/25, on the right is treated with fusion protein. (Original magnification: ×200)
-
The image on the left is immunohistochemistry of paraffin-embedded Human breast cancer tissue using CSB-PA265524(RMDN3 Antibody) at dilution 1/25, on the right is treated with fusion protein. (Original magnification: ×200)
-
-
其他:
產(chǎn)品詳情
-
Uniprot No.:
-
基因名:RMDN3
-
別名:RMDN3 antibody; FAM82A2 antibody; FAM82C antibody; PTPIP51 antibody; hucep-10 antibody; UNQ3122/PRO10274 antibody; Regulator of microtubule dynamics protein 3 antibody; RMD-3 antibody; hRMD-3 antibody; Cerebral protein 10 antibody; Protein FAM82A2 antibody; Protein FAM82C antibody; Protein tyrosine phosphatase-interacting protein 51 antibody; TCPTP-interacting protein 51 antibody
-
宿主:Rabbit
-
反應種屬:Human,Mouse,Rat
-
免疫原:Fusion protein of Human RMDN3
-
免疫原種屬:Homo sapiens (Human)
-
標記方式:Non-conjugated
-
抗體亞型:IgG
-
純化方式:Antigen affinity purification
-
濃度:It differs from different batches. Please contact us to confirm it.
-
保存緩沖液:-20°C, pH7.4 PBS, 0.05% NaN3, 40% Glycerol
-
產(chǎn)品提供形式:Liquid
-
應用范圍:ELISA,IHC
-
推薦稀釋比:
Application Recommended Dilution ELISA 1:1000-1:2000 IHC 1:25-1:100 -
Protocols:
-
儲存條件:Upon receipt, store at -20°C or -80°C. Avoid repeated freeze.
-
貨期:Basically, we can dispatch the products out in 1-3 working days after receiving your orders. Delivery time maybe differs from different purchasing way or location, please kindly consult your local distributors for specific delivery time.
-
用途:For Research Use Only. Not for use in diagnostic or therapeutic procedures.
相關產(chǎn)品
靶點詳情
-
功能:Involved in cellular calcium homeostasis regulation. May participate in differentiation and apoptosis of keratinocytes. Overexpression induces apoptosis.
-
基因功能參考文獻:
- Study shows that the VAPB-PTPIP51 tethers regulate autophagy and demonstrates that overexpression of VAPB or PTPIP51 to tighten endoplasmic reticulum-mitochondria contacts impairs, whereas small interfering RNA-mediated loss of VAPB or PTPIP51 to loosen contacts stimulates, autophagosome formation. PMID: 28132811
- the latest findings concerning PTPIP51 protein function, regulation and protein complex formation with regard to the involved signaling pathways and subcellular compartments (review) PMID: 27734150
- High PTPIP51 expression is associated with glioblastoma. PMID: 25862004
- PTPIP51 is regulated by its phosphorylation status combined with a thereby induced subcellular redistribution. PMID: 24501773
- The presented data confirms a tyrosine phosphorylation-dependent interaction of PTPIP51 with 14-3-3beta and Raf-1 in vivo and a tyrosine-dependent interaction profile with DAGKalpha and PKA. PMID: 22544307
- In glioblastoma PTPIP51 expression increases with the grade of malignancy and PTPIP51 interacts in situ with 14-3-3ss and PTP1B. PMID: 21972092
- PTPIP51 is phosphorylated by Lyn and c-Src kinases lacking dephosphorylation by PTP1B in acute myeloid leukemia. PMID: 21513978
- PTPIP51 expression was restricted to myeloid precursor cells undergoing differentiation. In blood cells therefore, PTPIP51 expression is restricted to differentiating and mature neutrophil granulocytes. PMID: 20627780
- PTPIP51 might be involved in the regulation of cellular processes associated with differentiation, movement, or cytoskeletal organization PMID: 15609043
- PTPIP51 is a mitochondrial protein with apoptosis-inducing function and that the N-terminal TM domain is required for both the correct targeting of the protein to mitochondria and its apoptotic functions. PMID: 16820967
- PTPIP51 and PTP1B, play a role in differentiation and apoptosis of the cytotrophoblast and syncytiotrophoblast, respectively. Moreover, PTPIP51 may also serve as a cellular signaling partner in angiogenesis and vascular remodeling. PMID: 18854601
- FAM82A2 is expressed in keratinocyte carcinoma and their surrounding stroma. PMID: 19012732
- The results clearly point toward a strong association between PTPIP51 expression and differentiation in human muscle cells. PMID: 19124842
- The promoter methylation status of PTPIP51 seems to influence the expression of PTPIP51, which was seen as elevated in the prostate carcinoma. PMID: 19691131
顯示更多
收起更多
-
亞細胞定位:Mitochondrion outer membrane; Single-pass membrane protein. Cytoplasm. Nucleus. Cytoplasm, cytoskeleton, spindle. Cytoplasm, cytoskeleton, spindle pole.
-
蛋白家族:RMDN family
-
組織特異性:Present at high level in epidermis and seminiferous epithelium: while basal cells in the epidermis and spermatogonia show no perceptible amount, keratinocytes of suprabasal layers and differentiating first-order spermatocytes up to spermatids exhibit high
-
數(shù)據(jù)庫鏈接:
Most popular with customers
-
-
YWHAB Recombinant Monoclonal Antibody
Applications: ELISA, WB, IHC, IF, FC
Species Reactivity: Human, Mouse, Rat
-
-
-
-
-
-